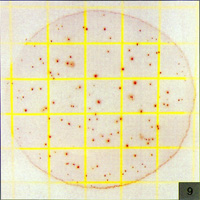

|
3M细菌总数测试片操作以及判读
|
|
一、测试细菌总数 操作方法
|
|
 1、未开封时,冷藏于≤8℃(≤46℉),并在保存期内用完,高温度时,凝固水可以排除,包装物最好于室温启开。 1、未开封时,冷藏于≤8℃(≤46℉),并在保存期内用完,高温度时,凝固水可以排除,包装物最好于室温启开。 |
 2、已开封的,将封口以胶带封紧。 2、已开封的,将封口以胶带封紧。 |
 3、保存再封的袋于≤25℃(≤77℉)和温度<50%,不要冷藏已开启的包装袋,并于一个月内使用完。 3、保存再封的袋于≤25℃(≤77℉)和温度<50%,不要冷藏已开启的包装袋,并于一个月内使用完。 |
 4、制备1:10和更大稀释的食物样品稀释液,0称取或吸取食物样品,置入适宜的无菌容器内,如均质袋、稀释瓶、WhirlPak bag或者其他灭菌容器内. 4、制备1:10和更大稀释的食物样品稀释液,0称取或吸取食物样品,置入适宜的无菌容器内,如均质袋、稀释瓶、WhirlPak bag或者其他灭菌容器内. |
 5、加入适量的无菌稀释液,包括Buffered peptone Buffer(IDF phopsphate buffer ,用0.0425g/L的KH2PO4调PH7.2) 、0.1%的蛋白胶水(ISO方法6887) 、缓冲蛋白胶水(ISO方法6579) 、盐溶液(0.85-0.90%)、bisulfite-free letheen broth或蒸馏水. 5、加入适量的无菌稀释液,包括Buffered peptone Buffer(IDF phopsphate buffer ,用0.0425g/L的KH2PO4调PH7.2) 、0.1%的蛋白胶水(ISO方法6887) 、缓冲蛋白胶水(ISO方法6579) 、盐溶液(0.85-0.90%)、bisulfite-free letheen broth或蒸馏水. 不可使用含有枸橼酸盐、酸性亚硫酸盐或硫代硫酸盐的缓冲液. 因为它们能抑止菌生长。 |
 6、搅拌或均质样品。 6、搅拌或均质样品。样品的稀释液调PH6.5-7.2 对酸性样品的稀释液用IN NaOH |
 7、将测试片置于平坦表面处,揭开上层膜。 7、将测试片置于平坦表面处,揭开上层膜。 |
 8、使用吸管将1mL样液垂直滴加在测试片的中央处。 8、使用吸管将1mL样液垂直滴加在测试片的中央处。 |
 9、允许使用上层膜直接落下,切勿向下滚动上层膜。 9、允许使用上层膜直接落下,切勿向下滚动上层膜。 |
 10、使用压板隆起面底朝下,放置在上层膜中央处。 10、使用压板隆起面底朝下,放置在上层膜中央处。 |
 11、轻轻的压下,使样液均匀覆盖于圆形的培养面积上,切勿扭转压板。 11、轻轻的压下,使样液均匀覆盖于圆形的培养面积上,切勿扭转压板。 |
 12、拿起压板,静置至少1分钟以使培养基凝固。 12、拿起压板,静置至少1分钟以使培养基凝固。 |
 13、测试片的透明面朝上,可堆叠至20片,对有一定湿度养箱能保持最少份损失是需要的。 13、测试片的透明面朝上,可堆叠至20片,对有一定湿度养箱能保持最少份损失是需要的。 |
 14、可目视及用标准菌落计数器或其它的照明放大镜计数,并可参考判读卡计算菌落数。 14、可目视及用标准菌落计数器或其它的照明放大镜计数,并可参考判读卡计算菌落数。 |
 15、可以分离菌落作进一步鉴定,即掀起上层膜,由培养胶上挑取单个菌落。 15、可以分离菌落作进一步鉴定,即掀起上层膜,由培养胶上挑取单个菌落。 |
|
| 二、测试细菌总数 判读方法 | |
 Aerobic bacteria count=152 Aerobic bacteria count=152测试片中含有一种红色指示染剂可使菌落着色,计算所有红色菌落(不论其大小和颜色深浅均计算之). |
 Count=0 Count=0在petrifilm AC测试片上,很容易解释,图2测试片上没有任何菌落生长. |
 Count=16 Count=16图3示有不多的菌落. |
 Count=143 Count=143Petrifilm AC测试片菌落数适宜计数范围是25-250,见图4 |
 Count=560 Count=560测试片面积约为20cm2,当菌落数超过250个,如图5所示,为了估计菌落数,可选择其中一个或数个有代表性菌落的小方格(1cm2),计算平均菌落数,再乘以20可得到整个测试片上的菌落数 |
 Count=tntc(estimated count=103) Count=tntc(estimated count=103)图6所示petrifilm AC测试片上菌落太多而无法计数(tntc) |
 count=tntc(Estimated count=105) count=tntc(Estimated count=105) 有很多高数量菌落,使整个生长区变粉色,如图7所示,你仅可在生长区边缘现观察到单个菌落,应计录为菌落太多无法计数(TNTC) |
 count=tntc(Estimated count=103) count=tntc(Estimated count=103)有时菌落分布出现不均衡,如图8所示,这也记录为TNTC. |
Count=tntc(Estimated count=107) Count=tntc(Estimated count=107)在图9中petrifilm AC测试片上的菌落,最先粗略一看是可计数的,然而,你密切注意到生长区边缘,能看到高密度的菌落,应记录为TNTC |
 Estimated count=160 Estimated count=160很少数菌种会液化petrifilm AC测试片上的培养基,如图10所示.若有这种现象发生,可选择没有液化区的几个有代表性菌落的小方格(1cm2),计算平均菌落数.不要计数液化区内的红点. |
 Count=83 Count=83因为在petrifilm AC测试片上菌落是红色的,你会和不透明的不规则形状的事物颗粒区分开,见圆圈1和2. |

 |
|
|
| 


